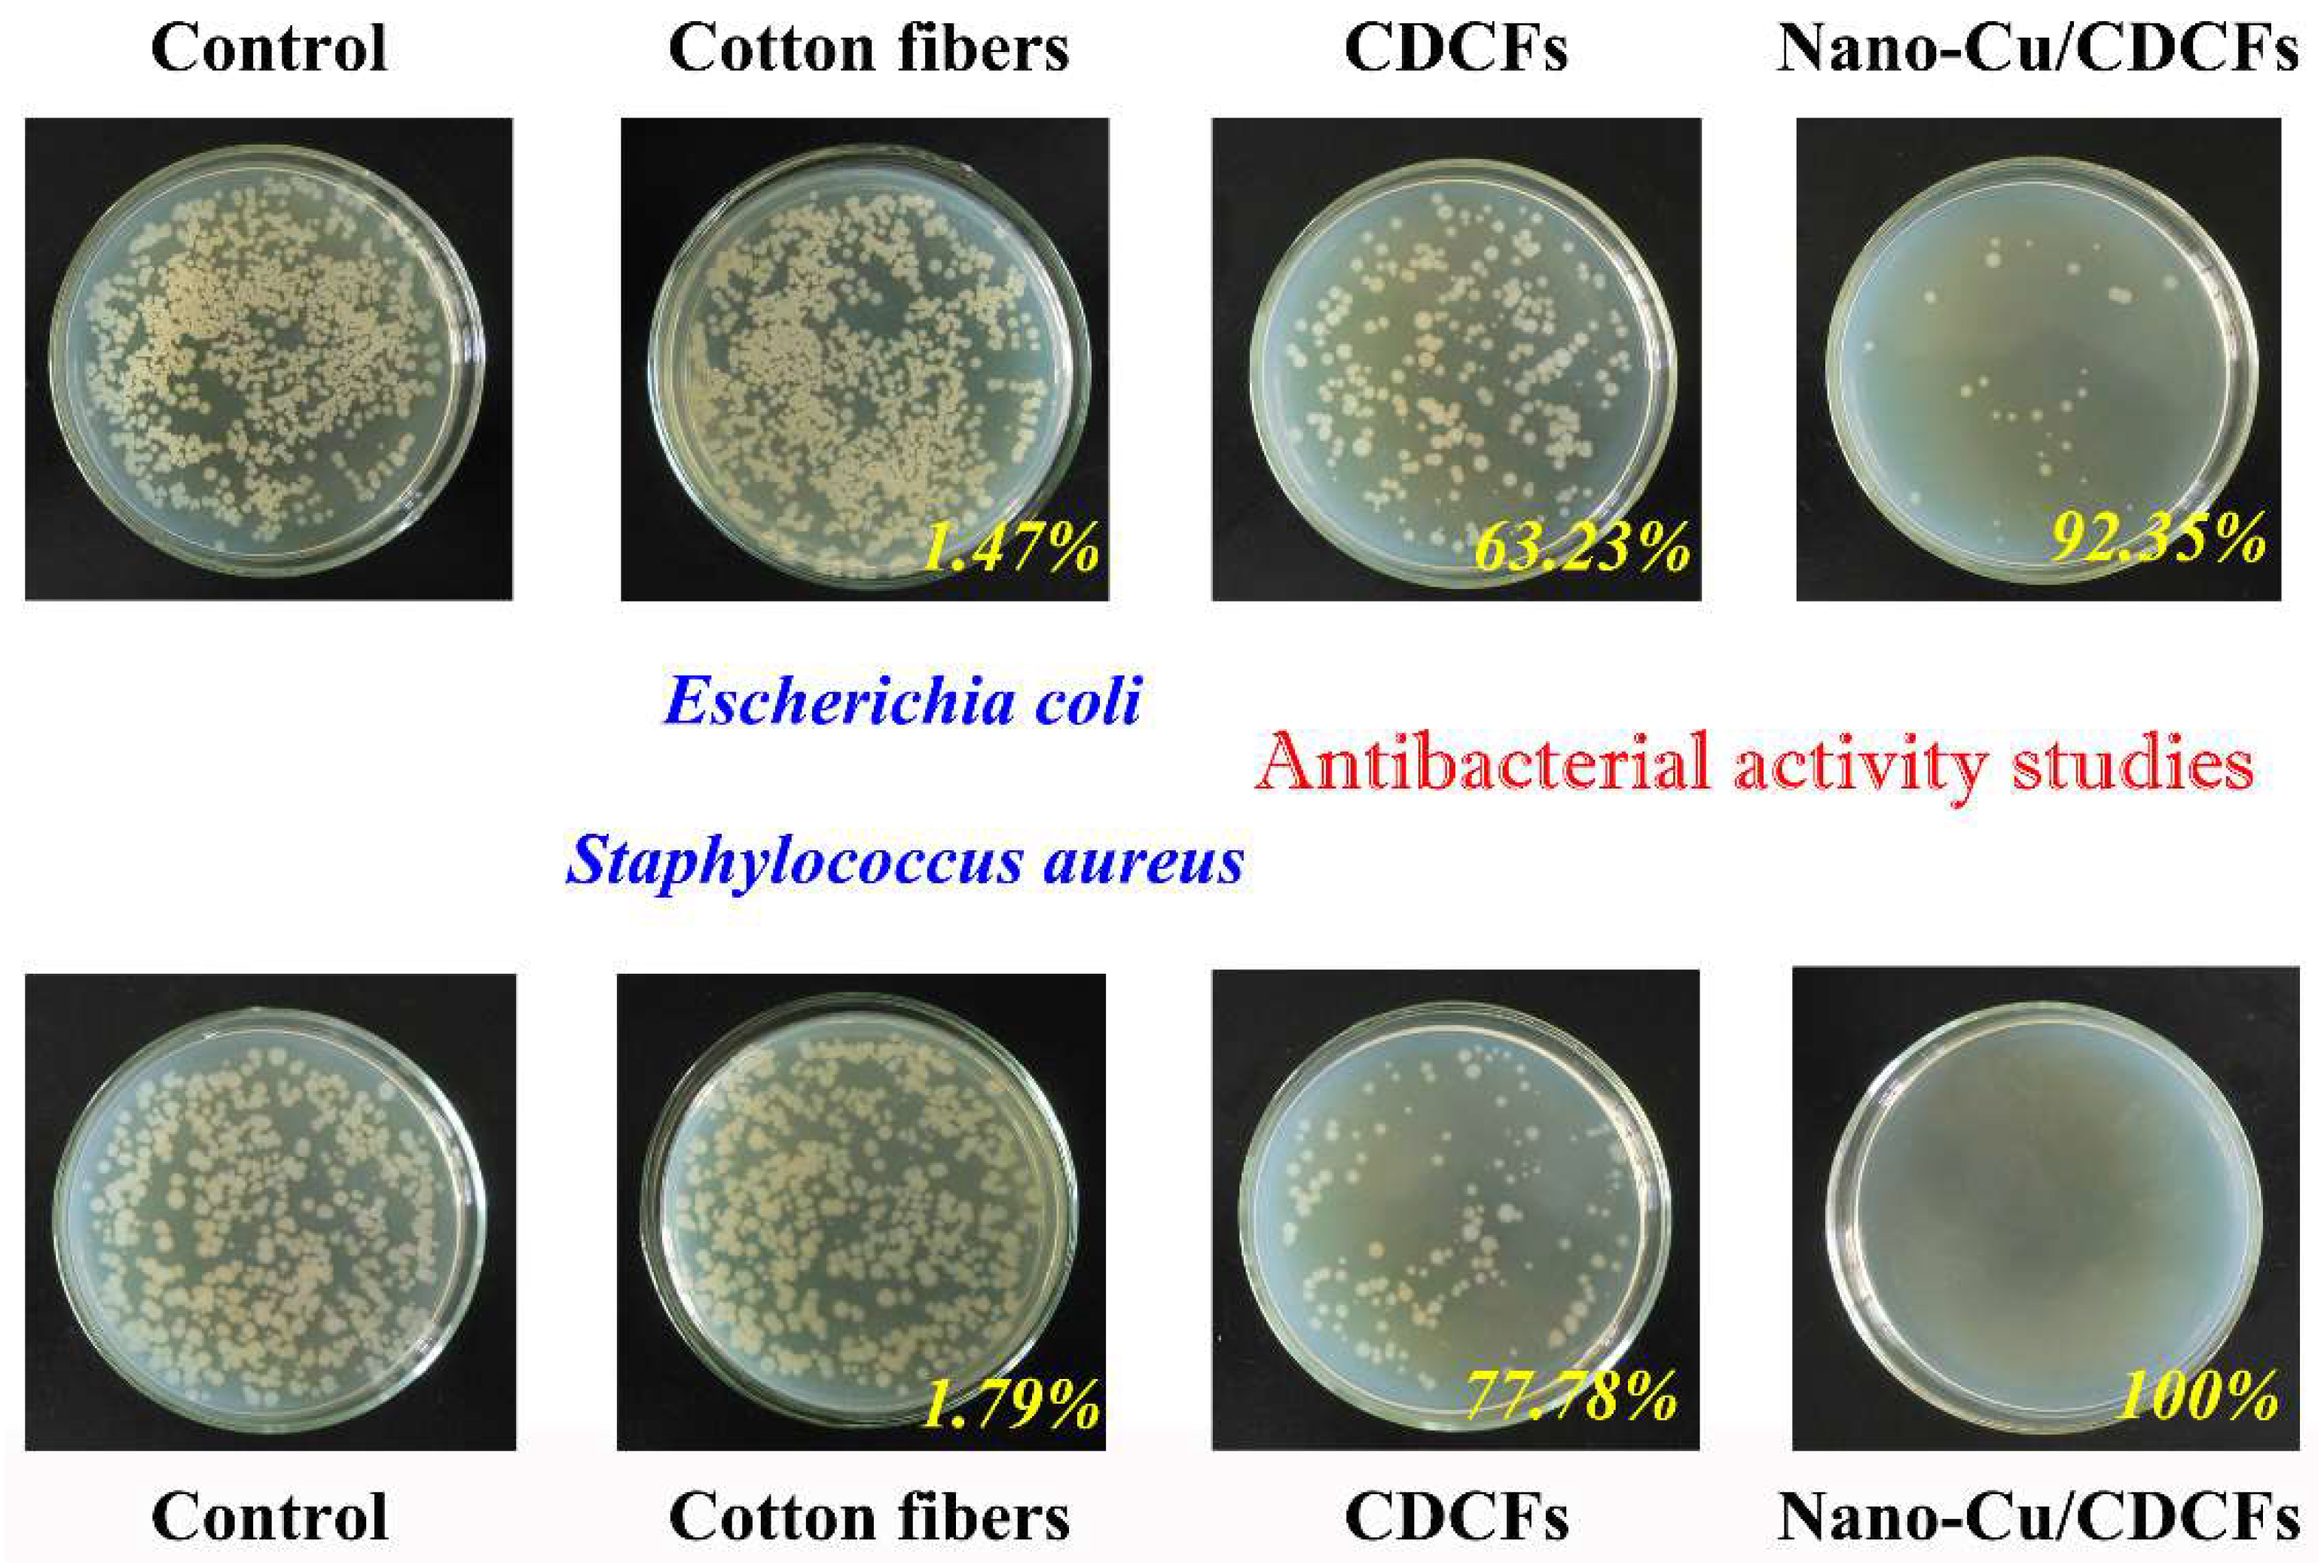

Carbon Fibers Encapsulated with Nano-Copper: A Core–Shell Structured Composite for Antibacterial and Electromagnetic Interference Shielding Applications
Abstract
:1. Introduction
2. Experimental Section
2.1. Materials
2.2. Preparation of Nano-Cu/CDCFs Composite
2.3. Characterizations
2.4. Antibacterial Activity Studies
2.5. EMI Shielding Effectiveness Studies
3. Results and Discussion
3.1. Schematic Diagram for Preparation of Nano-Cu/CDCFs Composite
3.2. Morphology Observations, Elemental Analysis and Crystal Structure
3.3. Hydrophobic Property and Antibacterial Activity
3.4. EMI Shielding Properties
4. Conclusions
Author Contributions
Funding
Conflicts of Interest
References
- Han, R.; Zhang, L.; Song, C.; Zhang, M.; Zhu, H.; Zhang, L. Characterization of modified wheat straw, kinetic and equilibrium study about copper ion and methylene blue adsorption in batch mode. Carbohydr. Polym. 2010, 79, 1140–1149. [Google Scholar] [CrossRef]
- Li, D.; Zhu, F.Z.; Li, J.Y.; Na, P.; Wang, N. Preparation and Characterization of Cellulose Fibers from Corn Straw as Natural Oil Sorbents. Ind. Eng. Chem. Res. 2013, 52, 516–524. [Google Scholar] [CrossRef]
- Lv, S.; Fu, F.; Wang, S.; Huang, J.; Hu, L. Novel wood-based all-solid-state flexible supercapacitors fabricated with a natural porous wood slice and polypyrrole. RSC Adv. 2015, 5, 2813–2818. [Google Scholar] [CrossRef]
- Jiao, Y.; Wan, C.; Li, J. Scalable synthesis and characterization of free-standing supercapacitor electrode using natural wood as a green substrate to support rod-shaped polyaniline. J. Mater. Sci. Mater. Electron. 2017, 28, 2634–2641. [Google Scholar] [CrossRef]
- Zhou, Q.; Gong, W.; Xie, C.; Yang, D.; Ling, X.; Yuan, X.; Chen, S.; Liu, X. Removal of Neutral Red from aqueous solution by adsorption on spent cottonseed hull substrate. J. Hazard. Mater. 2011, 185, 502–506. [Google Scholar] [CrossRef]
- Chen, C.; Zhang, Y.; Li, Y.; Dai, J.; Song, J.; Yao, Y.; Gong, Y.; Kierzewski, I.; Xie, J.; Hu, L. All-wood, low tortuosity, aqueous, biodegradable supercapacitors with ultra-high capacitance. Energy Environ. Sci. 2017, 10, 538–545. [Google Scholar] [CrossRef]
- Wang, L.; Gao, B.; Peng, C.; Peng, X.; Fu, J.; Chu, P.K.; Huo, K. Bamboo leaf derived ultrafine Si nanoparticles and Si/C nanocomposites for high-performance Li-ion battery anodes. Nanoscale 2015, 7, 13840–13847. [Google Scholar] [CrossRef] [PubMed]
- Khalil, H.P.S.A.; Bhat, A.H.; Yusra, A.F.I. Green composites from sustainable cellulose nanofibrils: A review. Carbohydr. Polym. 2012, 87, 963–979. [Google Scholar] [CrossRef]
- Yang, Q.; Fukuzumi, H.; Saito, T.; Isogai, A.; Zhang, L. Transparent cellulose films with high gas barrier properties fabricated from aqueous alkali/urea solutions. Biomacromolecules 2011, 12, 2766–2771. [Google Scholar] [CrossRef] [PubMed]
- Kim, J.-H.; Kim, J.-H.; Choi, E.-S.; Yu, H.K.; Kim, J.H.; Wu, Q.; Chun, S.-J.; Lee, S.-Y.; Lee, S.-Y. Colloidal silica nanoparticle-assisted structural control of cellulose nanofiber paper separators for lithium-ion batteries. J. Power Sources 2013, 242, 533–540. [Google Scholar] [CrossRef]
- Wang, Q.; Cai, J.; Zhang, L.; Xu, M.; Cheng, H.; Han, C.C.; Kuga, S.; Xiao, J.; Xiao, R. A bioplastic with high strength constructed from a cellulose hydrogel by changing the aggregated structure. J. Mater. Chem. A 2013, 1, 6678–6686. [Google Scholar] [CrossRef]
- Wan, C.; Li, J. Facile synthesis of well-dispersed superparamagnetic γ-Fe2O3 nanoparticles encapsulated in three-dimensional architectures of cellulose aerogels and their applications for Cr(VI) removal from contaminated water. ACS Sustain. Chem. Eng. 2015, 3, 2142–2152. [Google Scholar] [CrossRef]
- Wan, C.; Li, J. Cellulose aerogels functionalized with polypyrrole and silver nanoparticles: In-situ synthesis, characterization and antibacterial activity. Carbohydr. Polym. 2016, 146, 362–367. [Google Scholar] [CrossRef] [PubMed]
- Lu, Y.; Liu, H.; Gao, R.; Xiao, S.; Zhang, M.; Yin, Y.; Wang, S.; Li, J.; Yang, D. Coherent-interface-assembled Ag2O-anchored nanofibrillated cellulose porous aerogels for radioactive iodine capture. ACS Appl. Mater. Interfaces 2016, 8, 29179–29185. [Google Scholar] [CrossRef]
- Moon, R.J.; Martini, A.; Nairn, J.; Simonsen, J.; Youngblood, J. Cellulose nanomaterials review: Structure, properties and nanocomposites. Chem. Soc. Rev. 2011, 40, 3941–3994. [Google Scholar] [CrossRef] [PubMed]
- Wan, C.; Li, J. Embedding ZnO nanorods into porous cellulose aerogels via a facile one-step low-temperature hydrothermal method. Mater. Des. 2015, 83, 620–625. [Google Scholar] [CrossRef]
- Shi, Z.; Gao, H.; Feng, J.; Ding, B.; Cao, X.; Kuga, S.; Wang, Y.; Zhang, L.; Cai, J. In situ synthesis of robust conductive cellulose/polypyrrole composite aerogels and their potential application in nerve regeneration. Angew. Chem. Int. Ed. 2014, 53, 5380–5384. [Google Scholar] [CrossRef]
- Yin, Y.; Huang, R.; Zhang, W.; Zhang, M.; Wang, C. Superhydrophobic–superhydrophilic switchable wettability via TiO2 photoinduction electrochemical deposition on cellulose substrate. Chem. Eng. J. 2016, 289, 99–105. [Google Scholar] [CrossRef]
- Zhang, X.; Lin, Z.; Chen, B.; Zhang, W.; Sharma, S.; Gu, W.; Deng, Y. Solid-state flexible polyaniline/silver cellulose nanofibrils aerogel supercapacitors. J. Power Sources 2014, 246, 283–289. [Google Scholar] [CrossRef]
- Kemell, M.; Pore, V.; Ritala, M.; Leskelä, M.; Lindén, M. Atomic layer deposition in nanometer-level replication of cellulosic substances and preparation of photocatalytic TiO2/cellulose composites. J. Am. Chem. Soc. 2005, 127, 14178–14179. [Google Scholar] [CrossRef]
- Korhonen, J.T.; Hiekkataipale, P.; Malm, J.; Karppinen, M.; Ikkala, O.; Ras, R.H.A. Inorganic hollow nanotube aerogels by atomic layer deposition onto native nanocellulose templates. ACS Nano 2011, 5, 1967–1974. [Google Scholar] [CrossRef] [PubMed]
- Kelly, P.J.; Arnell, R.D. Magnetron sputtering: A review of recent developments and applications. Vacuum 2000, 56, 159–172. [Google Scholar] [CrossRef]
- Wan, C.; Jiao, Y.; Liang, D.; Wu, Y.; Li, J. A geologic architecture system-inspired micro-/nano-heterostructure design for high-performance energy storage. Adv. Energy Mater. 2018, 33, 1802388. [Google Scholar] [CrossRef]
- Sarakinos, K.; Alami, J.; Konstantinidis, S. High power pulsed magnetron sputtering: A review on scientific and engineering state of the art. Surf. Coat. Technol. 2010, 204, 1661–1684. [Google Scholar] [CrossRef]
- Alexeeva, O.K.; Fateev, V.N. Application of the magnetron sputtering for nanostructured electrocatalysts synthesis. Int. J. Hydrog. Energy 2016, 41, 3373–3386. [Google Scholar] [CrossRef]
- Wang, Q.; Xiao, S.; Shi, S.Q.; Xu, S.; Cai, L. Self-bonded natural fiber product with high hydrophobic and EMI shielding performance via magnetron sputtering Cu film. Appl. Surf. Sci. 2019, 475, 947–952. [Google Scholar] [CrossRef]
- Wan, C.; Jiao, Y.; Li, J. A cellulose fibers-supported hierarchical forest-like cuprous oxide/copper array architecture as a flexible and free-standing electrode for symmetric supercapacitors. J. Mater. Chem. A 2017, 5, 17267–17278. [Google Scholar] [CrossRef]
- Daoud, W.A.; Xin, J.H.; Zhang, Y.H. Surface functionalization of cellulose fibers with titanium dioxide nanoparticles and their combined bactericidal activities. Surf. Sci. 2005, 599, 69–75. [Google Scholar] [CrossRef]
- Mi, L.; Licina, G.A.; Jiang, S. Nonantibiotic-based pseudomonas aeruginosa biofilm inhibition with osmoprotectant analogues. ACS Sustain. Chem. Eng. 2014, 2, 2448–2453. [Google Scholar] [CrossRef]
- Nishiyama, Y.; Langan, P.; Chanzy, H. Crystal structure and hydrogen-bonding system in cellulose Iβ from synchrotron x-ray and neutron fiber diffraction. J. Am. Chem. Soc. 2002, 124, 9074–9082. [Google Scholar] [CrossRef]
- Popov, V.V.; Orlova, T.S.; Magarino, E.E.; Bautista, M.A.; Martínez-Fernández, J. Specific features of electrical properties of porous biocarbons prepared from beech wood and wood artificial fiberboards. Phys. Solid State 2011, 53, 276–283. [Google Scholar] [CrossRef]
- Dandekar, A.; Baker, R.T.K.; Vannice, M.A. Characterization of activated carbon, graphitized carbon fibers and synthetic diamond powder using TPD and DRIFTS. Carbon 1998, 36, 1821–1831. [Google Scholar] [CrossRef]
- Bhushan, B.; Jung, Y.C. Natural and biomimetic artificial surfaces for superhydrophobicity, self-cleaning, low adhesion, and drag reduction. Prog. Mater. Sci. 2011, 56, 1–108. [Google Scholar] [CrossRef]
- Kim, M.J.; Kim, Y.K.; Kim, K.H.; Kwon, T.Y. Shear bond strengths of various luting cements to zirconia ceramic: Surface chemical aspects. J. Dent. 2011, 39, 795–803. [Google Scholar] [CrossRef] [PubMed]
- Wan, C.; Jiao, Y.; Sun, Q.; Li, J. Preparation, characterization, and antibacterial properties of silver nanoparticles embedded into cellulose aerogels. Polym. Compos. 2016, 37, 1137–1142. [Google Scholar] [CrossRef]
- Longano, D.; Ditaranto, N.; Cioffi, N.; di Niso, F.; Sibillano, T.; Ancona, A.; Conte, A.; del Nobile, M.A.; Sabbatini, L.; Torsi, L. Analytical characterization of laser-generated copper nanoparticles for antibacterial composite food packaging. Anal. Bioanal. Chem. 2012, 403, 1179–1186. [Google Scholar] [CrossRef]
- Peña, M.M.O.; Koch, K.A.; Thiele, D.J. Dynamic regulation of copper uptake and detoxification genes in Saccharomyces cerevisiae. Mol. Cell. Biol. 1998, 18, 2514–2523. [Google Scholar] [CrossRef]
- Kang, S.; Herzberg, M.; Rodrigues, D.F.; Elimelech, M. Antibacterial effects of carbon nanotubes: Size does matter! Langmuir 2008, 24, 6409–6413. [Google Scholar] [CrossRef]
- Wan, C.; Jiao, Y.; Qiang, T.; Li, J. Cellulose-derived carbon aerogels supported goethite (α-FeOOH) nanoneedles and nanoflowers for electromagnetic interference shielding. Carbohydr. Polym. 2017, 156, 427–434. [Google Scholar] [CrossRef]
- Wan, C.; Li, J. Synthesis and electromagnetic interference shielding of cellulose-derived carbon aerogels functionalized with α-Fe2O3 and polypyrrole. Carbohydr. Polym. 2017, 161, 158–165. [Google Scholar] [CrossRef]
- Li, N.; Huang, Y.; Du, F.; He, X.; Lin, X.; Gao, H.; Ma, Y.; Li, F.; Chen, Y.; Eklund, P.C. Electromagnetic interference (EMI) shielding of single-walled carbon nanotube epoxy composites. Nano Lett. 2006, 6, 1141–1145. [Google Scholar] [CrossRef] [PubMed]
- Akşit, A.C.; Onar, N.; Ebeoglugil, M.F.; Birlik, I.; Celik, E. Ozdemir, Ismail, Electromagnetic and electrical properties of coated cotton fabric with barium ferrite doped polyaniline film. J. Appl. Polym. Sci. 2009, 113, 358–366. [Google Scholar] [CrossRef]
- Yim, Y.J.; Rhee, K.Y.; Park, S.J. Electromagnetic interference shielding effectiveness of nickel-plated MWCNTs/high-density polyethylene composites. Compos. Part B Eng. 2016, 98, 120–125. [Google Scholar] [CrossRef]
- Hu, T.; Wang, J.; Wang, J. Electromagnetic interference shielding properties of carbon fiber cloth based composites with different layer orientation. Mater. Lett. 2015, 158, 163–166. [Google Scholar] [CrossRef]
- Song, W.-L.; Wang, J.; Fan, L.-Z.; Li, Y.; Wang, C.-Y.; Cao, M.-S. Interfacial engineering of carbon nanofiber–graphene–carbon nanofiber heterojunctions in flexible lightweight electromagnetic shielding networks. ACS Appl. Mater. Interfaces 2014, 6, 10516–10523. [Google Scholar] [CrossRef] [PubMed]
- Cao, W.T.; Chen, F.F.; Zhu, Y.J.; Zhang, Y.G.; Jiang, Y.Y.; Ma, M.G.; Chen, F. Binary strengthening and toughening of MXene/cellulose nanofiber composite paper with nacre-inspired structure and superior electromagnetic interference shielding properties. ACS Nano 2018, 12, 4583–4593. [Google Scholar] [CrossRef]
- Lee, J.; Liu, Y.; Liu, Y.; Park, S.J.; Park, M.; Kim, H.Y. Ultrahigh electromagnetic interference shielding performance of lightweight, flexible, and highly conductive copper-clad carbon fiber nonwoven fabrics. J. Mater. Chem. C 2017, 5, 7853–7861. [Google Scholar] [CrossRef]
- Raagulan, K.; Braveenth, R.; Jang, H.; Lee, Y.S.; Yang, C.M.; Kim, B.M.; Moon, J.J.; Chai, K. Electromagnetic shielding by MXene-Graphene-PVDF composite with hydrophobic, lightweight and flexible graphene coated fabric. Materials 2018, 11, 1803. [Google Scholar] [CrossRef]
- Song, Q.; Ye, F.; Yin, X.; Li, W.; Li, H.; Liu, Y.; Li, K.; Xie, K.; Li, X.; Fu, Q.; et al. Carbon nanotube–multilayered graphene edge plane core–shell hybrid foams for ultrahigh-performance electromagnetic-interference shielding. Adv. Mater. 2017, 29, 1701583. [Google Scholar] [CrossRef] [PubMed]
- Micheli, D.; Vricella, A.; Pastore, R.; Marchetti, M. Synthesis and electromagnetic characterization of frequency selective radar absorbing materials using carbon nanopowders. Carbon 2014, 77, 756–774. [Google Scholar] [CrossRef]
- Zhao, Z.; Zheng, W.; Yu, W.; Long, B. Electrical conductivity of poly(vinylidene fluoride)/carbon nanotube composites with a spherical substructure. Carbon 2009, 47, 2118–2120. [Google Scholar] [CrossRef]
- Zhao, B.; Park, C.B. Tunable Electromagn. shielding properties of conductive poly(vinylidene fluoride)/Ni chain composite films with negative permittivity. J. Mater. Chem. C 2017, 5, 6954–6961. [Google Scholar] [CrossRef]
- Ohlan, A.; Singh, K.; Chandra, A.; Dhawan, S.K. Microwave absorption behavior of core−shell structured poly (3,4-ethylenedioxy thiophene)−barium ferrite nanocomposites. ACS Appl. Mater. Interfaces 2010, 2, 927–933. [Google Scholar] [CrossRef] [PubMed]

| Composites | Maximum SEtotal/dB | SSE/dB cm3 g−1 | SSEt/dB cm2 g−1 | Ref. |
|---|---|---|---|---|
| Scoured canvas fabric/polyaniline | 13 | – | – | [42] |
| Nickel-plated multiwalled carbon nanotubes/high-density polyethylene composites | 16 | – | – | [43] |
| Carbonyliron powder-carbon fiber cloth/epoxy resin | 47 | – | – | [44] |
| Neat carbon nanofiber networks | 18 | 180 | 6667 | [45] |
| d-Ti3C2Tx/cellulose nanofiber composite paper | 25.8 | 12.4 | 2647 | [46] |
| Carbon nanofiber–graphene nanosheet networks | 28 | 280 | 10,370 | [45] |
| Nano-Cu/CDCFs | 29.3 | 92 | 4621 | This work |
© 2019 by the authors. Licensee MDPI, Basel, Switzerland. This article is an open access article distributed under the terms and conditions of the Creative Commons Attribution (CC BY) license (http://creativecommons.org/licenses/by/4.0/).
Share and Cite
Jiao, Y.; Wan, C.; Zhang, W.; Bao, W.; Li, J. Carbon Fibers Encapsulated with Nano-Copper: A Core–Shell Structured Composite for Antibacterial and Electromagnetic Interference Shielding Applications. Nanomaterials 2019, 9, 460. https://doi.org/10.3390/nano9030460
Jiao Y, Wan C, Zhang W, Bao W, Li J. Carbon Fibers Encapsulated with Nano-Copper: A Core–Shell Structured Composite for Antibacterial and Electromagnetic Interference Shielding Applications. Nanomaterials. 2019; 9(3):460. https://doi.org/10.3390/nano9030460
Chicago/Turabian StyleJiao, Yue, Caichao Wan, Wenbo Zhang, Wenhui Bao, and Jian Li. 2019. "Carbon Fibers Encapsulated with Nano-Copper: A Core–Shell Structured Composite for Antibacterial and Electromagnetic Interference Shielding Applications" Nanomaterials 9, no. 3: 460. https://doi.org/10.3390/nano9030460
APA StyleJiao, Y., Wan, C., Zhang, W., Bao, W., & Li, J. (2019). Carbon Fibers Encapsulated with Nano-Copper: A Core–Shell Structured Composite for Antibacterial and Electromagnetic Interference Shielding Applications. Nanomaterials, 9(3), 460. https://doi.org/10.3390/nano9030460

